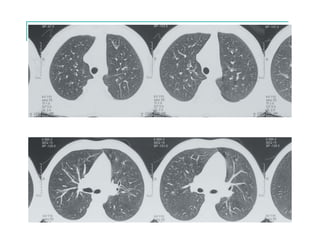

Este documento presenta información sobre la fibrosis quística, incluyendo su genética, fisiopatología, manifestaciones clínicas, diagnóstico y evolución. La fibrosis quística es una enfermedad autosómica recesiva causada por mutaciones en el gen CFTR que afecta múltiples sistemas, principalmente el pulmonar. Su diagnóstico se basa en hallazgos clínicos, pruebas de sudor positivas y/o identificación de mutaciones. La enfermedad pulmonar progresiva es la principal































![El porcentaje de caída del FEV1 predice mortalidad
100
80
60
40
20
Age (years)
5 10 15 20 25 30 35 400
MeanFEV1%pred
Una caída lenta del FEV1 mejoraría la sobrevida
Konstan MW et al. J Cystic Fibrosis 2009; 8 [suppl 1] S15-S19.](https://image.slidesharecdn.com/zaragozafibrosisquistica-191115163848/85/fibrosis-quistica-mesa-redonda-32-320.jpg)